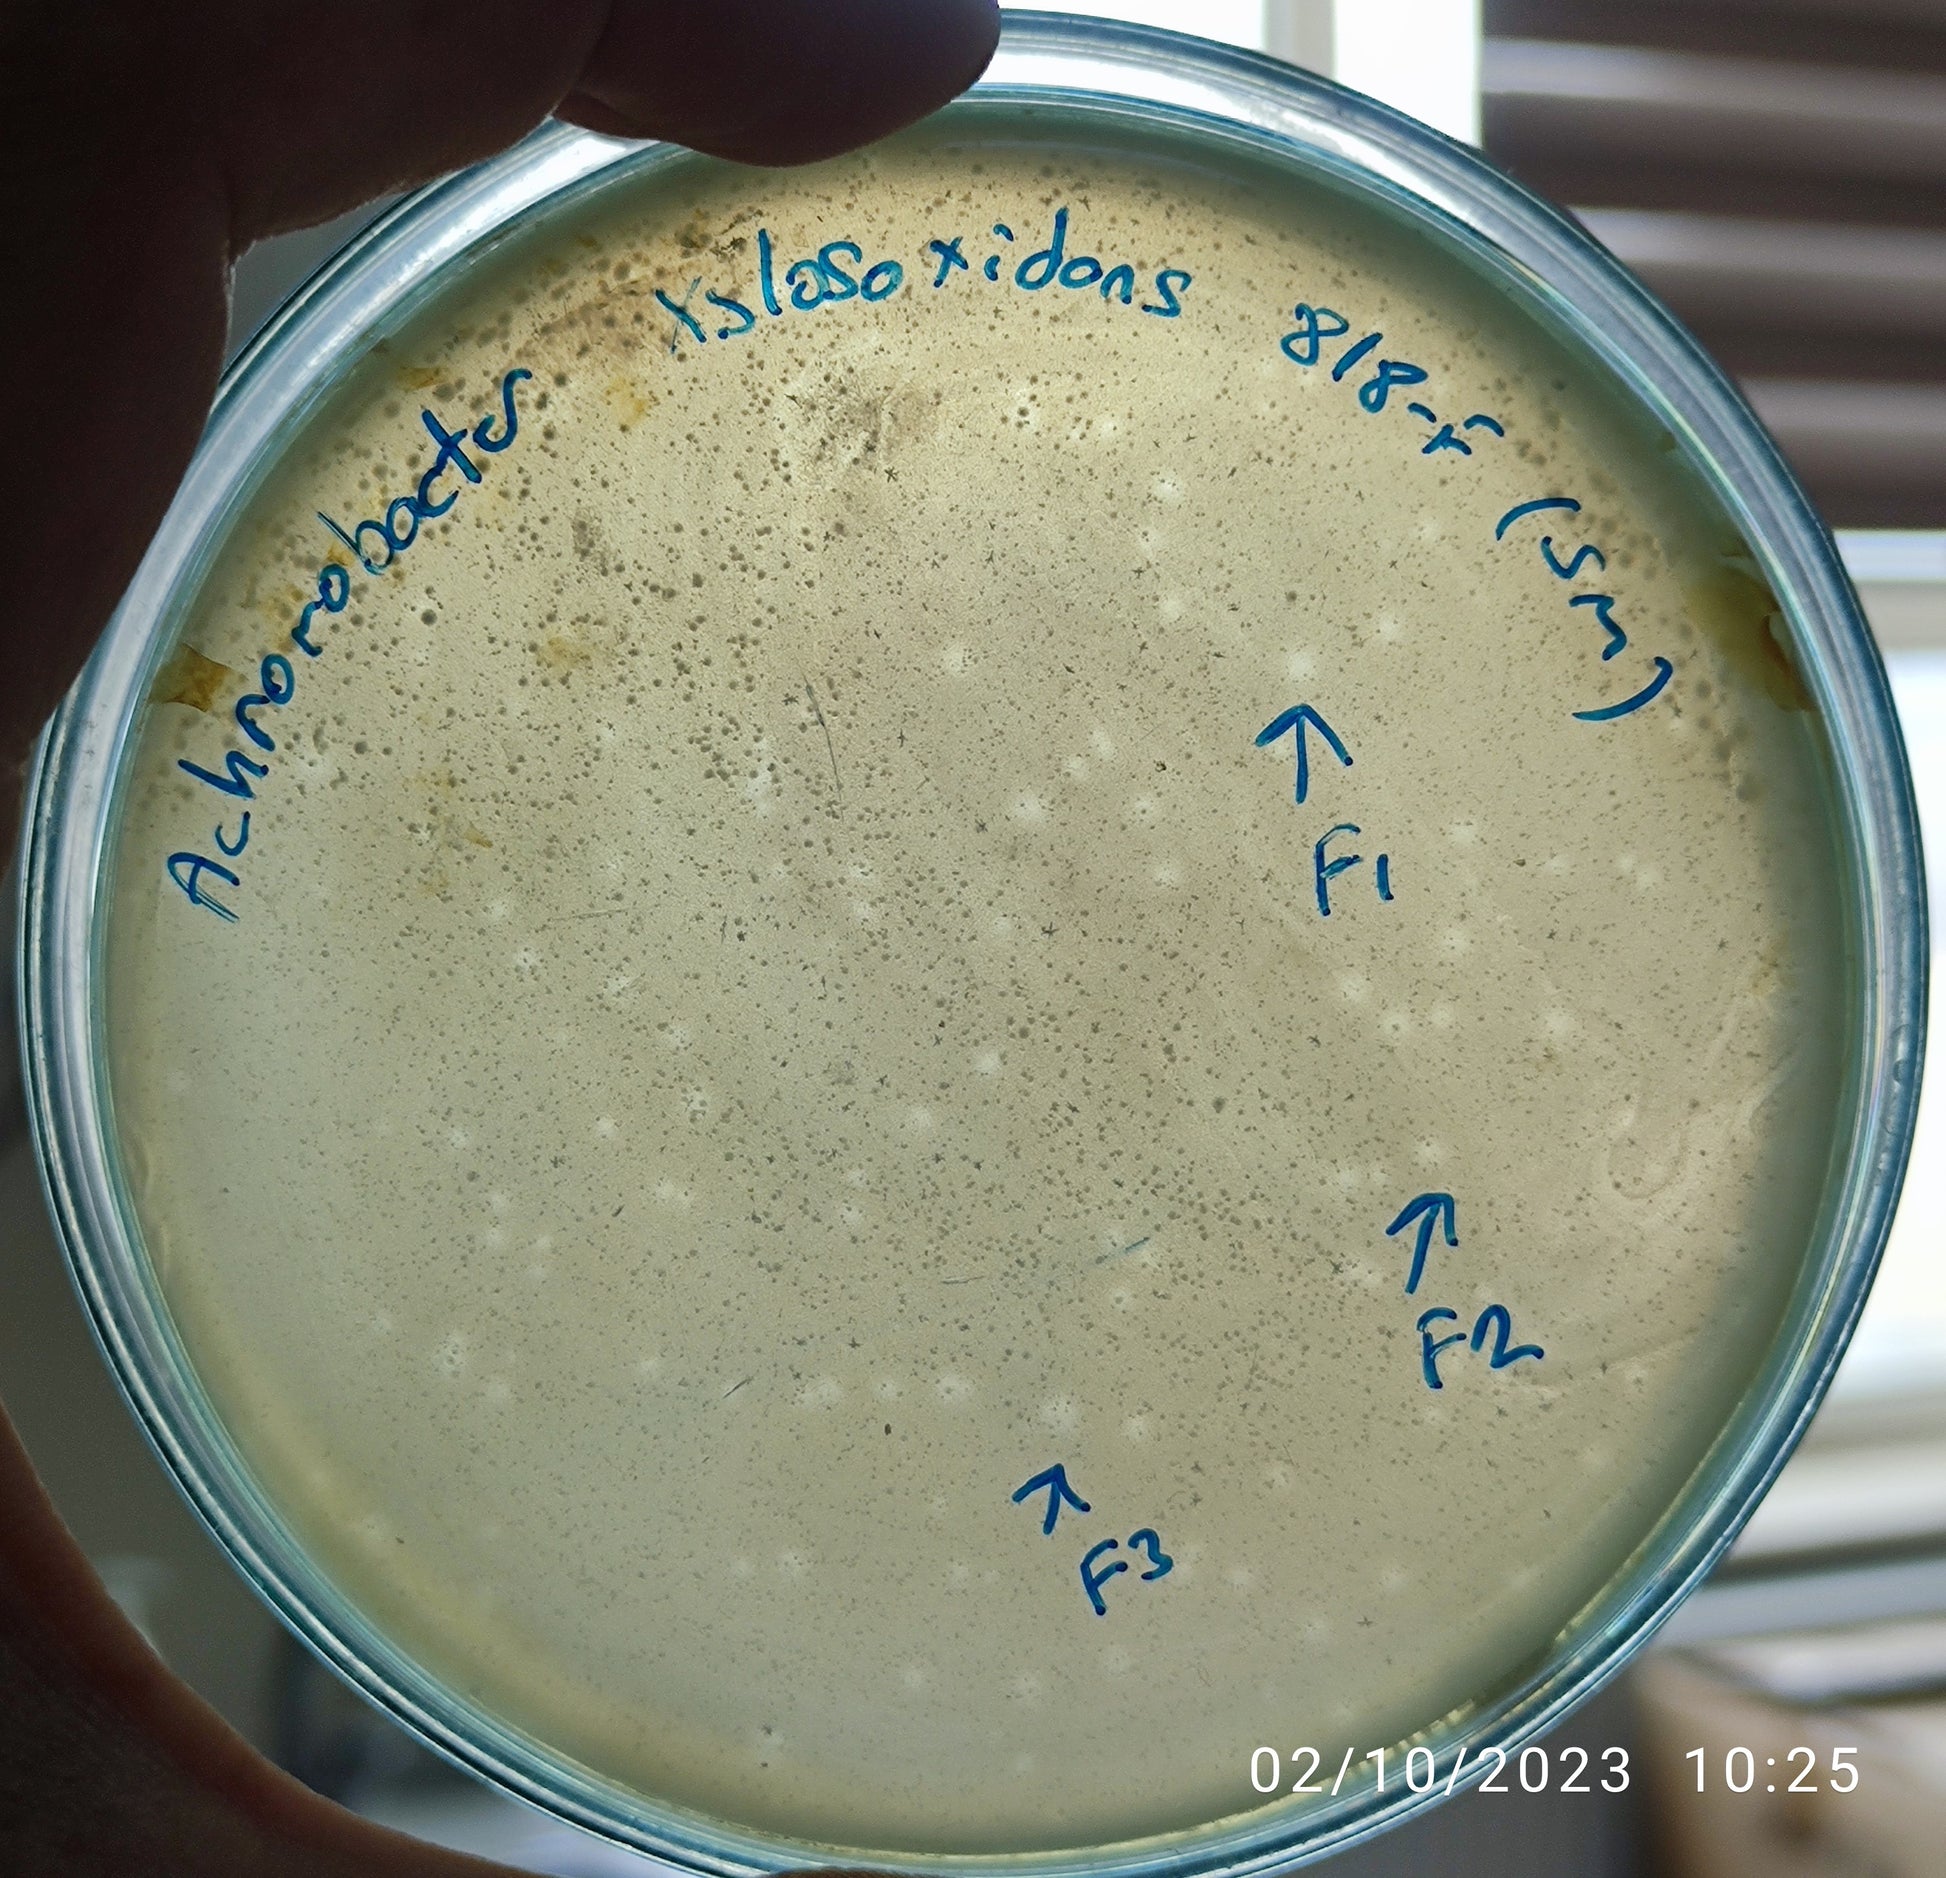
Achromobacter xylosoxidans bacteriophage 200818F Mikroliz

Achromobacter ist eine Bakterien-Gattung aus der Familie der Alcaligenaceae, die zur Ordnung der Burkholderiales gehört. Es handelt sich um gramnegative, stäbchenförmige Bakterien. Der Katalase- und Oxidase-Test fällt positiv aus. Sie sind durch peritriche Geißeln beweglich und kommen im Boden und Wasser vor.
Stoffwechsel
Der Stoffwechsel von Achromobacter ist in der Regel chemoorganotroph, die Arten nutzen verschiedene organischen Verbindungen wie zum Beispiel Aminosäuren für das Wachstum. Allerdings sind einige Arten, wie Achromobacter ruhlandii Wasserstoffoxidierer, man spricht auch von Knallgasbakterien. Sie gewinnen Energie durch die Oxidation von Wasserstoff (H2) mit Sauerstoff (O2) zu Wasser (H2O). Da es sich um anorganische Stoffe handelt, zählen sie zu den fakultativ chemolithotrophen Bakterien. Sie sind nicht obligat lithotroph, da sie, wenn die entsprechenden Umständen gegeben sind, zum chemoorganischen Stoffwechsel wechseln können und organische Substrate für den Energiestoffwechsel nutzen.
Die Arten von Achromobacter sind aerob, sie führen keine Fermentation (Gärung) durch. Einige Arten, wie zum Beispiel Achromobacter denitrificans können aber auch unter anaeroben Bedingungen existieren und führen dann im Energiestoffwechsel eine Denitrifikation durch. Man spricht auch von der Nitratatmung. Solche Bakterien reduzieren Stickstoffoxide wie Nitrat oder Nitrit unter anaeroben Bedingungen bis hin zu molekularen Stickstoff (N2). Auch in der eng verwandten Gattung Alcaligenes sind Nitratatmer anzutreffen, zum Beispiel die Art Alcaligenes faecalis. Dieser Stoffwechselweg ist innerhalb der Prokaryoten relativ weit verbreitet, einige weitere Beispiele sind Thiobacillus denitrificans (Familie Hydrogenophilaceae), Paracoccus denitrificans der Klasse Alpha-Proteobakterien, sowie einige Arten von Pseudomonas der Gamma-Proteobakterien.
Medizinische Bedeutung
Bei Achromobacter-Nachweis im Falle einer Infektion (etwa bei Mukoviszidose, wobei die pathogenetische Bedeutung unklar ist) kommt eine antimikrobielle Behandlung mit Meropenem oder Imipenem in Kombination mit Ciprofloxacin in Betracht. Gegen Aminoglykoside besteht eine Primärresistenz.
Systematik
Eine Auswahl von Arten:
- Achromobacter aegrifaciens Vandamme et al. 2014
- Achromobacter agilis Vandamme et al. 2016
- Achromobacter denitrificans (Rüger & Tan 1983) Coenye et al. 2003
- Achromobacter insolitus Coenye et al. 2003
- Achromobacter piechaudii (Kiredjian et al. 1986) Yabuuchi et al. 1998
- Achromobacter ruhlandii (Packer & Vishniac 1955) Yabuuchi et al. 1998
- Achromobacter spanius Coenye et al. 2003
- Achromobacter xylosoxidans (ex Yabuuchi & Ohyama 1971) Yabuuchi & Yano 1981
- Achromobacter xylosoxidans subsp. denitrificans (Rüger and Tan 1983) Yabuuchi et al. 1998, comb. nov.
- Achromobacter xylosoxidans subsp. xylosoxidans (ex Yabuuchi and Ohyama 1971) Yabuuchi and Yano 1981, comb. nov.
Literatur
- Michael T. Madigan, John M. Martinko, Jack Parker: Brock – Mikrobiologie. Hrsg.: Pearson Studium. 11. Auflage. München 2006, ISBN 3-8274-0566-1.
- George M. Garrity: Bergey's manual of systematic bacteriology. 2. Auflage. Springer, New York, 2005, Vol. 2: The Proteobacteria Part C: The Alpha-, Beta-, Delta-, and Epsilonproteabacteria ISBN 0-387-24145-0
- Martin Dworkin, Stanley Falkow, Eugene Rosenberg, Karl-Heinz Schleifer, Erko Stackebrandt (Hrsg.): The Prokaryotes, A Handbook of the Biology of Bacteria. 7 Bände, 3. Auflage, Springer-Verlag, New York u. a. O., 2006, ISBN 0-387-30740-0. Vol. 5: Proteobacteria: Alpha and Beta Subclass ISBN 0-387-30745-1.
Einzelnachweise